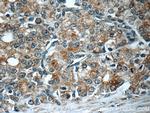
PREB Antibody in Immunohistochemistry (Paraffin) (IHC (P))

Search
Proteintech
PREB Polyclonal Antibody
{{$productOrderCtrl.translations['antibody.pdp.commerceCard.promotion.promotions']}}
{{$productOrderCtrl.translations['antibody.pdp.commerceCard.promotion.viewpromo']}}
{{$productOrderCtrl.translations['antibody.pdp.commerceCard.promotion.promocode']}}: {{promo.promoCode}} {{promo.promoTitle}} {{promo.promoDescription}}. {{$productOrderCtrl.translations['antibody.pdp.commerceCard.promotion.learnmore']}}

Please note: We are reviewing Western blot images included in the antibody testing data in our catalog, including those provided by third parties. Unless expressly labeled or annotated as “raw-unedited”, Western blot images included in the antibody testing data in our catalog may have been edited, optimized or otherwise adjusted for presentation.
产品信息
10146-2-AP
种属反应
已发表种属
宿主/亚型
分类
类型
抗原
偶联物
形式
浓度
规格
纯化类型
保存液
内含物
保存条件
运输条件
产品详细信息
Immunogen sequence: PFPLYALQV DPSTGLLIAA GGGGAAKTGI KNGVHFLQLE LINGRLSASL LHSHDTETRA TMNLALAGDI LAAGQDAHCQ LLRFQAHQQQ GNKAEKAGSK EQGPRQRKGA APAEKKCGAE TQHEGLELRV ENLQAVQTDF SSDPLQKVVC FNHDNTLLAT GGTDGYVRVW KVPSLEKVLE FKAHEGEIED L (13-202 aa encoded by BC002765)
靶标信息
Prolactin (PRL) expression in the pituitary is limited to specific cells. Pit-1 is a pituitary specific transcription factor that plays an important role in PRL expression, both in mature organism and during development. The PRL promoter contains numerous Pit-1 binding sites and these sites have been implicated in both basal level and kinase-mediated gene expression. The most proximal of these binding sites, termed 1P, has been shown to direct a response to numerous signals, such as cAMP and various G-proteins. A novel protein, termed PREB (prolactin regulatory element binding protein), has been recently identified that regulates PRL gene expression through the 1P site, though it contains no discernable DNA-binding motif. Recent studies suggest that PREB is encoded by a single-copy gene in both mice and humans and exhibits nuclear accumulation in pituitary cells. Evidence suggests that PREB is a novel transcription factor that assists in PRL expression whether alone, or in concert with Pit-1.
仅用于科研。不用于诊断过程。未经明确授权不得转售。
生物信息学
蛋白别名: Guanine nucleotide-exchange factor SEC12; mammalian guanine nucleotide exchange factor mSec12; Mammalian guanine nucleotide exchange factor Sec12; mSec12; Prolactin regulatory element-binding protein
基因别名: C85705; PREB; SEC12
UniProt ID: (Mouse) Q9WUQ2
Entrez Gene ID: (Mouse) 50907




